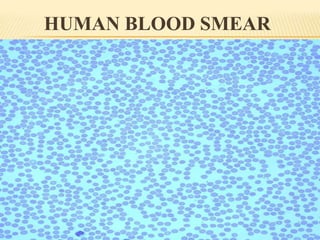
HUMAN BLOOD SMEAR
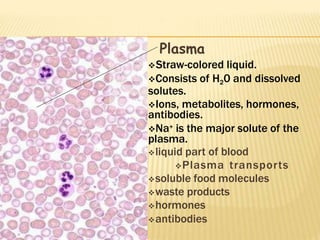
Plasma
Straw-colored liquid.
Consists of H20 and dissolved
solutes.
Ions, metabolites, hormones,
antibodies.
Na+ is the major solute of the
plasma.
liquid part of blood
Plasma transports
soluble food molecules
waste products
hormones
antibodies
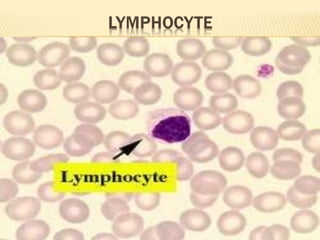

Hematology is the study of blood, blood-forming organs, and blood diseases. It includes treatment of blood disorders and cancers. Blood is composed of plasma and formed elements including red blood cells, white blood cells, and platelets. Red blood cells contain hemoglobin and carry oxygen throughout the body. White blood cells are part of the immune system and help fight infection. Platelets help with blood clotting. Blood is produced through hematopoiesis in the bone marrow and regulated by various factors.